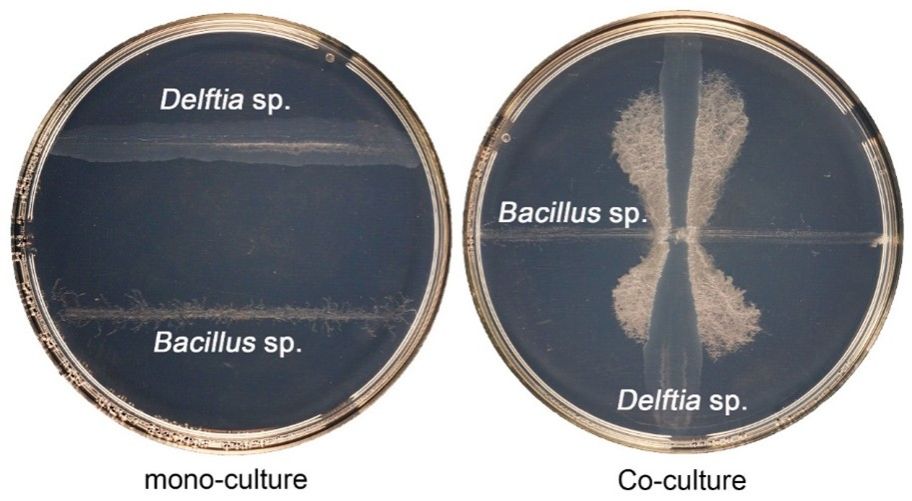

土壤是一个动态的生态系统,微生物群落的物种间相互作用以及与环境的相互反馈是微生物生存和生长的重要影响因素,对微生物的群落结构、多样性以及生态功能都会产生重要影响。尽管土壤微生物间的相互作用对土壤生态系统具有重要影响,但人们对这些相互作用的机制及其与元素生物地球化学循环之间的耦联关系仍知之甚少。
近期,汪鹏教授课题组利用前期构建的微生物无机砷传感器(Anal. Chem. 2023, 95: 11467-11474)从砷污染土壤中偶然筛选到一对交叉互养土壤细菌,经鉴定为Bacillus sp.和Delftia sp.。它们常共生在一起,单独存在时生长极差(图1)。通过共培养实验、代谢产物分析等方法,揭示了两种菌株之间的双重互惠机制。菌株Bacillus sp.由于丙酮酸脱氢酶活性低,对丙酮酸的利用能力较差;菌株Delftia sp.由于缺乏己糖激酶和磷酸转移酶系统,不能利用葡萄糖。当单独生长时,菌株Bacillus sp.利用葡萄糖转化为丙酮酸,向环境介质中释放丙酮酸,使自身生长环境酸化,并最终导致自身死亡。然而,当菌株Bacillus sp.与Delftia sp.一起生长时,菌株Delftia sp.利用菌株Bacillus sp.释放的丙酮酸来满足能量需求,丙酮酸被Delftia sp.利用后,环境pH酸化得到缓解,从而使菌株Bacillus sp.免受丙酮酸诱导的生长抑制,两种菌株通过交叉互养促进彼此生长(第一重互惠)。这种交叉互养过程弥补了它们的代谢缺陷,使它们在土壤中的得以生存。
图1. Bacillus sp.和Delftia sp.的生长相互作用
进一步研究发现,这两种细菌能够使用砷作为武器,进一步增强它们对抗其它微生物的集体竞争力(图2)。菌株Delftia sp.能将相对无毒的一甲基五价砷[MAs(V)]还原为毒性强的一甲基三价砷[MAs(III)](一种抗生素),从而杀死或抑制竞争者,而菌株Bacillus sp.能将MAs(III)甲基化为无毒的二甲基五价砷DMAs(V)来解毒,从而不受MAs(III)的抑制作用。当菌株Delftia sp.和Bacillus sp.一起生长时,这两种砷的转化过程会得到增强。Delftia sp.和Bacillus sp.在砷转化方面的交互作用提高了它们相对于其他菌株的集体竞争力(第二重互惠)。进一步通过全国103份不同砷含量土壤的微生物16S rRNA数据分析,发现Delftia sp.和Bacillus sp.及其近亲细菌广泛共存于土壤中,并且它们的丰度随着土壤砷浓度的升高而增加,说明这类双重互惠在土壤微生物群落中是常见现象。

图2. 土壤中Delftia sp.和Bacillus sp.之间依赖于砷浓度的合作关系很常见。(A,B)添加不同浓度的MAs(V)或As(III)的土壤中Delftia sp.和Bacillus sp.的相对丰度变化;(C)从不同气候带收集的103个土壤样本分布;(D)Delftia sp.和Bacillus sp.的相对丰度之间的相关性;(E,F)Delftia sp.和Bacillus sp.的相对丰度与土壤砷浓度的相关性
综上,该研究揭示了两种土壤细菌Delftia sp.和Bacillus sp.之间一种新的双重互惠关系(图3)。这些细菌通过补偿彼此的碳代谢缺陷来交叉互养,并且通过产生和解毒含砷抗生素在微生物群落中获得集体竞争优势。鉴于砷在环境中普遍存在,基于碳代谢的交叉互养和使用砷作为微生物战争的武器可能是两种常见的微生物相互作用,对塑造微生物群落结构、维持微生物群落稳定性和多样性具有重要意义。

图3. Bacillus sp.和Delftia sp.在碳代谢和砷转化中的交叉互养相互作用模型
相关研究成果在微生物生态学期刊The ISME Journal上发表了题为"Two-tiered mutualism improves survival and competitiveness of cross-feeding soil bacteria"(2023)的论文,其中,av直播
博士生葛占标为论文第一作者,汪鹏教授为通讯作者,博士生翟志强、博士后戴军、谢婉滢副教授、黄科副教授、赵方杰教授以及瑞士联邦水科学与技术研究所David Johnson高级研究员也参与了该研究工作。该研究得到了国家重点研发计划项目、江苏省重点研发计划项目和中央高校基本科研业务费项目的资助。
全文链接://www.nature.com/articles/s41396-023-01519-5

 微信公众号
微信公众号